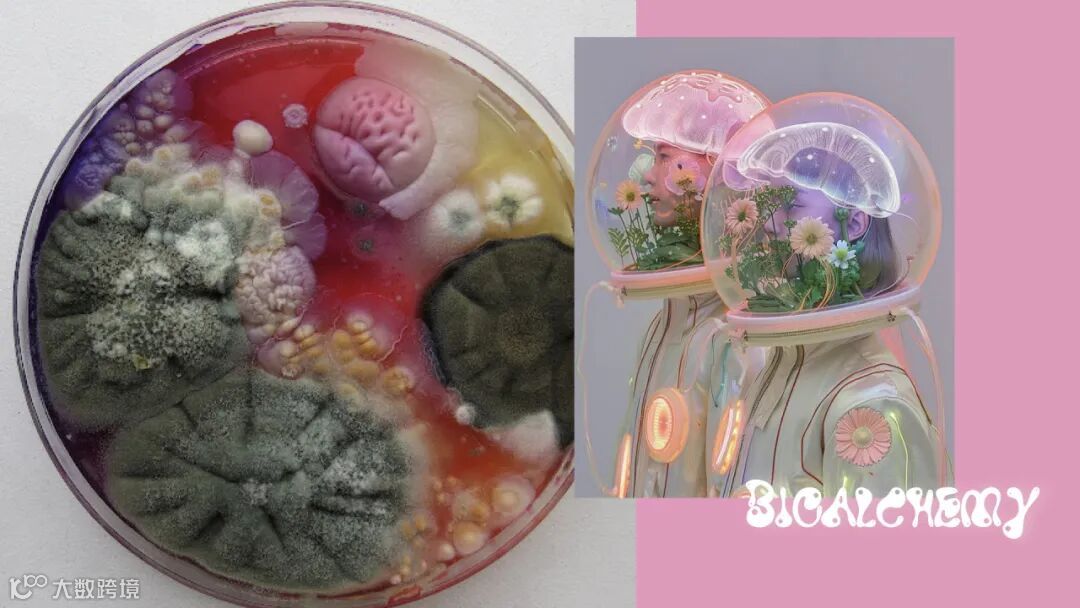

FW26 上海私享会
本季,UPW® 以 炼金实验室 为主题,探讨转化的精神。
这里的炼金术士,早已不追求点石成金的梦,而是致力于编制万物的灵魂。
废墟之上,昔日的辉煌早已崩塌为铁锈与碎片。断裂的金属、风蚀的布料、破败的器物……一切曾被使用、遗弃、遗忘的物件,如同尘封的记忆,静静散落在荒原上,等待命运的再次编织。
“关怀炼结,
爱意封存”
纤维炼金师们穿行于残骸之间,搜集遗落的文明碎片。他们解析材质,倾听记忆,以古老流传的炼金术重组物质的本源。他们将时间的沉淀与遗忘的伤痕,凝结为一缕缕新生的纤维——每一丝都承载着过往的痕迹,却又闪耀着未来的光芒。
一缕缕纤维,不再是简单的原料,而是再生的灵魂,是千锤百炼出的织物未来。



新品展示
左右滑动查看更多
Yak系列服装
本次展出了由 UPW® YAK 系列制作的牦牛绒服装系列。


Insight 视界

设计师 Yushang 分享本季 Insight 视界背后的故事。
本季 Insight 视界的五个故事
左右滑动查看更多
炼金术源自古代物质转化术,古人相信万物由土、气、火、水构成,借助能量或催化剂便可实现转化。虽然铅不能成金,但炼金术士对转化本质的执念,孕育了现代化学,也启发了哲学对万物流动与统一的思考。
在今日这个脆弱而多变的时代,变化早已成为常态。脆弱,代表高度敏感,任何细微变化都可引发连锁反应;多变,则是宇宙永恒不息的本质。
客人们仔细观看织片
UPW® 希望用纤维完成一场现代炼金术:点“纱”成绿,让纱线承载情绪、工艺与可持续价值。围绕“转化”关键词,本季策划五个生动的概念故事,旨在展现 UPW® 纱线的多样可能性。
趋势与机遇
市场专员 Whitney 分享趋势洞察:
73%品牌正面临“趋势同质化”与“供应链可持续”双重压力。

UPW®提出两大应对策略:
① 以纱线情绪价值提升开发效率与产品溢价,数据显示带情绪标签针织品溢价率达28%。
② 回归质朴自然,打造#EarthyHues大地色系,呼应74%亚太消费者“放慢节奏”的生活诉求。

关键词:
#田园生活 #长期主义 #传统手工艺

设计方向:
•松弛感纱线:粗花呢、手工绞花、天然纹理
•自然取色:赭石、橄榄、红土、黄金棕榈
•情绪叙事: 安全感、返璞归真、慢节奏

三大灵感场景:
•归园田居:田园+波西米亚,唤醒城市游子乡野记忆
•山涧旅者:自然派运动,禅意化情绪设计
•返璞松弛:做旧、手工、中式田园元素,回应慢生活趋势

销售与客户对接



展厅


为客人们准备了精美的茶歇


NFC与原材料的展示
礼品
UPW®特别定制桌上绿植,作为“炼金实验室”主题的纪念物,承载可持续理念与自然关怀。


上海私享会圆满收官,感谢每一位远道而来的设计师与合作伙伴。
在这个脆弱而多变的时代,UPW®期待与你一起,完成属于我们的现代炼金术。

— END —
本文部分图片来源于网络,版权归原作者所有
如对版权问题有疑问,请私信
我们会尽快处理,谢谢